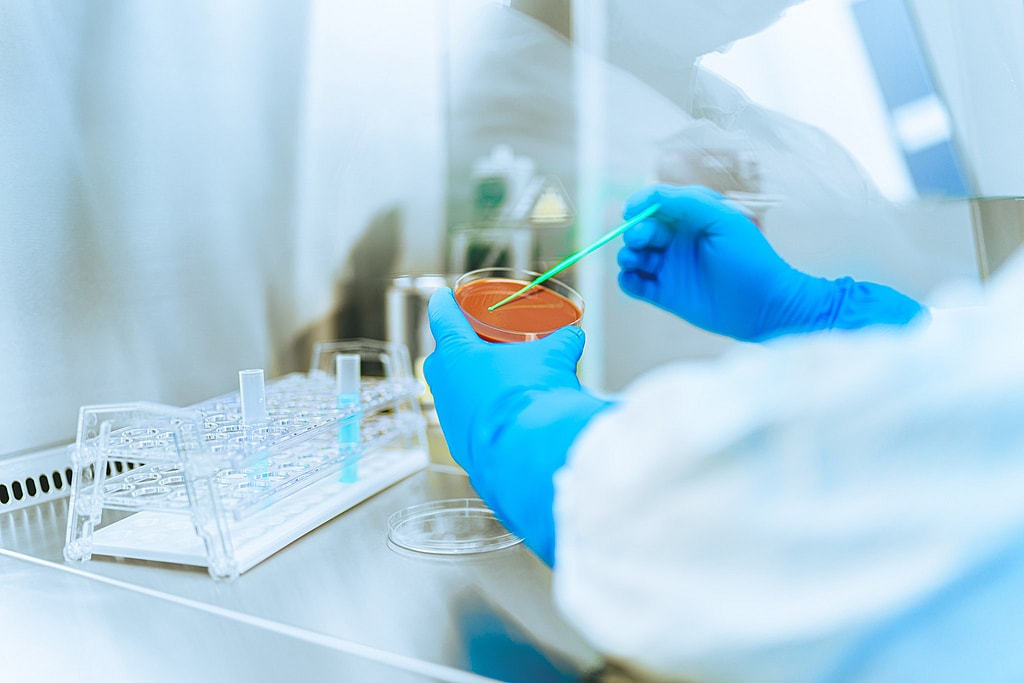
Listing cover image

OM Pharma is a global Geneva-based biopharmaceutical company. It is a leader in the prevention of recurrent respiratory and urinary tract infections, also active in the treatment of vascular diseases.
Products, services, technology
OM Pharma’s product portfolio comprises products for respiratory tract infections, lower urinary tract infections, chronic venous insufficiency, microangiopathy (for example diabetic retinopathy), hemorrhoids and menometrorrhagia (heavy menstrual bleeding).
- http://www.ompharma.com
- +41 22 783 12 11
- Send an email